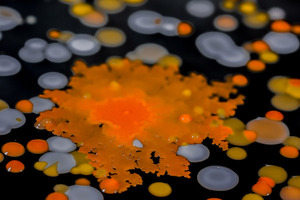

Microbial Life: A Universe at the Edge of Sight
Saturday, Mar 31, 2018 9:00a -
5:00p
Repeats weekly
Where:
Harvard Museum of Natural History
26 Oxford Street
Cambridge, MA 02138
Admission:
$Standard Museum Admission.
Categories:
University
Event website:
https://hmnh.harvard.edu/news/microbial-life-universe-edge-sight
Thriving all around, and even within us, is a minute universe of astonishing and diverse lifeforms so small, they cannot be seen by the human eye. Everything from our food, to the air we breathe, to the forest ecosystem, is based on the activity of microbes. These astonishing and diverse lifeforms that live inside and all around us are so small they cannot be seen by the human eye -- until now. The Harvard Museum of Natural History presents a new, unique exhibition, Microbial Life: A Universe at the Edge of Sight. Taking museum visitors through a multi-sensory journey into this fascinating, invisible realm, the Microbial Life odyssey provides a unique opportunity to experience the wonders of microbial activity and the surprisingly stunning beauty of bacterial forms. From a full-scale model kitchen to captivating models from the Harvard Medical School, visitors can delve into the fascinating, invisible realm of microbes: Earth’s first inhabitants.
-

Sponsored -

SponsoredGuided Tour of Historic Castle Hill o n the Crane Estate: Round Trip Transportation from Boston Included!
Saturday, Jul 05, 2025 11:30a
Crane Estate
-

SponsoredDay Trip from Boston: Kayak Castle Neck River at Crane Estate
Saturday, Jul 05, 2025 11:30a
Crane Beach
-

SponsoredAffordable Spanish Classes in Boston (in-person and online courses) | BASE
Monday, Jul 07, 2025 goes until 07/18
Boston Area Spanish Exchange (BASE)
-

SponsoredExplore The New England Botanic Garden at Tower Hill: Day Trip from Boston
Sunday, Jul 06, 2025 11:00a
New England Botanic Gardens at Tower Hill
-

SponsoredCurated Cuisine: Let’s talk lobster with Row 34’s Jeremy Sewall and Select Oyster’s Michael Serpa
Monday, Jul 14, 2025 6:30p
WBUR CitySpace
-

SponsoredRockport Guided Coastal Kayak or SUP Excursion from Boston
Saturday, Jul 05, 2025 12:30p
Rockport Harbor